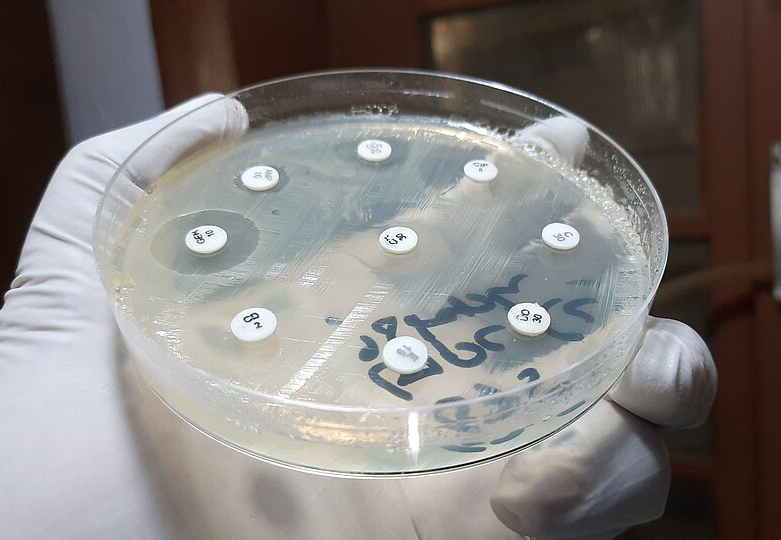

Variation in Populations (College Board AP® Biology): Study Guide
Genetic diversity & resilience to environmental pressure
Genetic diversity is the variety of alleles within a species or population
Maintaining genetic diversity is crucial for the long-term survival and adaptability of populations in changing environments
Under new selection pressures, alleles that were beneficial in one environment may become harmful
This will alter the fitness of individuals, influencing survival and reproduction rates
Populations with high genetic diversity are more likely to include individuals with traits that help them adapt and withstand new selective pressures
Populations with low genetic diversity are more vulnerable to change
There is an increase in the risk of decline or extinction, as fewer individuals possess adaptive traits
Example: California condors
The California condor (Gymnogyps californianus) is the largest North American land bird
Populations declined in the 20th century due to DDT use, poaching, and lead poisoning
Low population numbers caused low genetic diversity, reducing resilience to environmental challenges

CC BY-SA 2.0 Don Graham, via Wikimedia Commons (opens in a new tab)
Example: black-footed ferrets
The black-footed ferret (Mustela nigripes) is a critically endangered predator that depends heavily on prairie dogs for food
Prairie dog declines from habitat loss and pest extermination have removed its main food source, and the ferret’s low genetic diversity increases vulnerability to environmental change, further threatening its survival

USFWS Mountain-Prairie, Public domain, via Wikimedia Commons (opens in a new tab)
Example: prairie chickens
The prairie chicken (Tympanuchus cupido), also called a boomer for its mating call, is highly endangered in North America
Its prairie habitat has been largely lost to agriculture during the 20th–21st centuries
Population declines have caused a severe loss of genetic diversity, which has been linked to poor reproductive success and higher extinction risk

CC BY 2.0 Ron Knight, via Wikimedia Commons (opens in a new tab)
Example: potato blight
Potato blight is a disease caused by the protoctist Phytophthora infestans, which spreads via spores and causes dark brown marks on leaves that quickly spread between plants
The pathogen destroys potato and tomato crops, making them inedible
This highlights the need for genetic diversity in crops; different varieties carry different resistance alleles, so a genetically mixed or diverse set of crops is less likely to be wiped out by a single pathogen

I. Sáček, CC0, via Wikimedia Commons (opens in a new tab)
Example: corn rust
Corn rust is a fungal disease affecting maize crops
Low genetic diversity in cultivated maize makes crops more vulnerable to widespread infection

Scot Nelson, Public Domain, via Flickr (opens in a new tab)
Example: antibiotic resistance in bacteria
A genetically diverse bacterial population is more likely to be able to respond to a new antibiotic in their environment:
Within a diverse bacterial population, some individuals may carry alleles that provide resistance to an antibiotic
When exposed to the antibiotic, any individuals with the resistance allele survive
Surviving bacteria are more likely to reproduce, passing on their resistance alleles to their offspring
Over several generations the frequency of the resistance allele increases, eventually resulting in an antibiotic-resistant strain of bacteria
Ajay Kumar Chaurasiya, CC BY-SA 4.0, via Wikimedia Commons (opens in a new tab)
Unlock more, it's free!
Did this page help you?